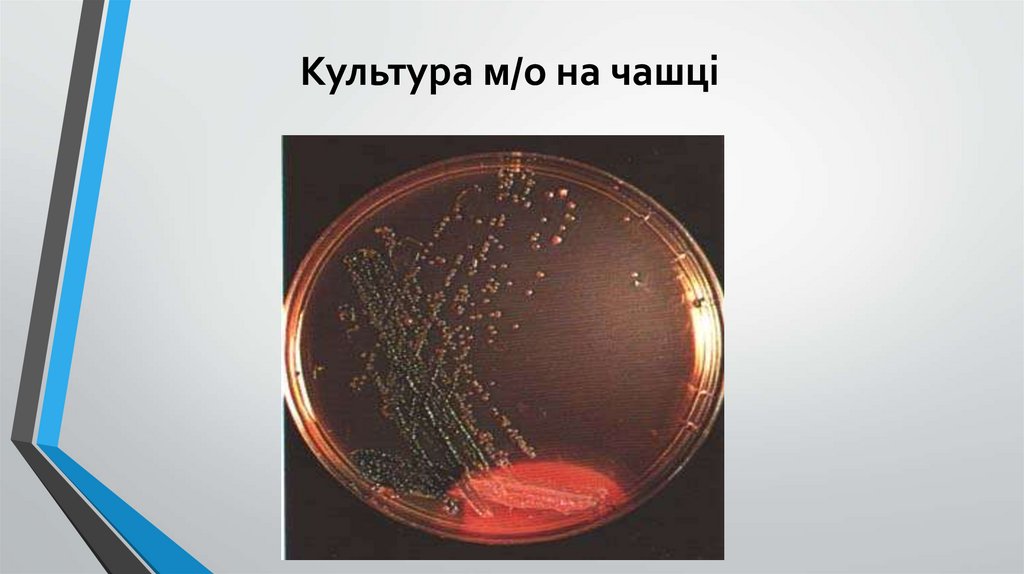

Similar presentations:
Методи діагностики інфекційних хвороб. Медсестринський процес при інфекційних хворобах
1.
Лекція 2Методи діагностики інфекційних хвороб.
Медсестринський процес при інфекційних
хворобах.
2.
3.
Методи діагностики інфекційних хворобКлінічні
Параклінічні
об’єктивні
анамнестичні
лабораторні
інструментальні
4.
АнамнестичніСкарги
Анамнез хвороби
Епідеміологічний анамнез
Анамнез життя
5.
Скаргидеталізація,
конкретизація
- коли почалася хвороба
Анамнез хвороби
- як перебігала
- яке було лікування застосовано
і ефект від нього
Епідеміологічний
анамнез
З’ясувати:
-Джерело інфекції
-Шлях передачі
-Імунний статус організму
Анамнез
життя
• умови проживання
• перенесені захворювання
• шкідливі звички
• алергологічний анамнез
6.
Контакт з хворим (дома, на роботі)Перебування в умовах багатолюддя
Джерело інфекції
Захворюваність в оточенні (в
місцевості)
Виїзд в неблагополучні території
7.
Які продукти вживавДоброякісність продуктів
Харчовий шлях
Як були приготовлені
Як зберігались
Хто ще їв, і чи були якісь
симптоми
8.
Яку воду вживає для питтязазвичай
Чи піддає кипятінню, очистці
Водний шлях
Можливість вживання води з
невідомих джерел
Про купання
9.
Миття рукКонтактнопобутовий
шлях
Власний посуд
Харчування у кафе, їдальнях
10.
Трансмісивнийшлях
Укуси кровосисних комах
11.
Поранення в забрудненихумовах
Укуси тварин, догляд за
тваринами
Контактно –
раневий
шлях
Переливання крові
Медичні та косметичні
маніпуляції
Вживання наркотичних
речовин (в/в)
12.
Об’єктивне обстеження•Огляд
•Пальпація
•Перкусія
•Аускультація
13.
Основні прояви інфекційних хвороб1)Гарячка
2)Інтоксикація
3)Висипання (на шкірі та слизових)
4)Збільшення печінки та селезінки (гепатоспленомегалія)
5)Лімфоаденопатія
14.
Симптом- це ознака патологічного стану чи хвороби, яку можнавизначити під час обстеження хворого, а також за допомогою
лабораторних, інструментальних методів дослідження.
патогномонічні
(провідні)
опорні
допоміжні
Синдром- група симптомів, поєднаних спільним патогенезом.
15.
Типи температурнихкривих
Постійна
Послаблювальна
(ремітуюча)
16.
ГектичнаПереміжна
(інтермітуюча)
17.
ПоворотнаХвилеподібна
18.
Екзантема- це висипання на шкірі.Енантема- висипання на слизових оболонках.
Екзантеми поділяються на первинні і вторинні
-розеола
-пляма
-еритема
-геморагія
-папула
-пустула
-горбик
-вузол
-міхур
-міхурець
-пухир
-луска
-пігментація
-виразка
-рубець
-тріщина
-ерозія
-екскоріація
-ліхеніфікація
-атрофія
-кірка
19.
Розеола-пляма (цятка) рожевого кольору до 5 мм, яка знакає під часнатискування і розтягування шкіри.
20.
Пляма- ділянка шкіри округлої форми, що розміщена на рівні шкіри,розміром 5-10мм і більше.
21.
Еритема- великі ділянки гіперемованої шкіри, які утворилисявнаслідок зливання великих плям.
22.
Геморагії- плями різної форми і розмірів, що утворились внаслідоккрововиливів.
23.
Папула- вузлик,що злегка піднімається над шкірою , має м’яку чи щільнуконсистенцію, розміром від 1 до 20мм.
24.
Горбик- обмежений щільний елемент рожево-червоного кольору, щовиступає над шкірою і має розмір від 3-5 до 20 мм.
25.
Вузол- щільний утвір, що знаходиться глибоко в шкірі , діаметром від 1 до 510см, може виразкуватися і рубцюватися.26.
Везикула (міхурець)- Міхур- ексудативний елемент,ексудативний елемент, що піднімається над
рівнем шкіри і розміром до 5 мм.
розміром від 5мм до 10см.
27.
Пустула- пухирець з мутним гнійним вмістом, що виступає над рівнемшкіри.
28.
ЛабораторніЗагальноклінічні
Специфічні
Загальний аналіз крові
Мікроскопічний
Загальний аналіз сечі
Бактеріологічний
Копрограма
Вірусологічний
Біологічний
Біохімічний аналіз крові
Імунологічний
Коагулограма
Алергологічний
Молекулярно-біологічний
29.
Специфічні методилабораторної діагностики:
-мікроскопічний
-бактеріологічний (культуральний)
-вірусологічний
-біологічний
-імунологічний (серологічний)
-алергологічний
-молекулярно-біологічний
30.
Мікроскопічний метод31.
Виготовлення мазка32.
Забарвлення мазка33.
34.
Культура м/о на чашці35.
Зараження курячого ембріону36.
Біологічний метод37.
Зараження піддослідних тварин38.
39.
Серологічний (імунологічний) методзаснований на специфічній взаємодії антигену з антитілом40.
Алергологічний метод41.
Молекулярно-біологічний метод- полягає увиявленні генетичного матеріалу (ДНК чи РНК) збудника.
42.
Інструментальніметоди
• Рентгенологічний
• Ендоскопічний
• Ультразвуковий
• Радіологічний
43.
Медсестринський процеспри інфекційних хворобах
І етап
медсестринське обстеження
ІІ етап
медсестринська діагностика
ІІІ етап
планування втручань
І етап
реалізація плану втручань
І етап
Оцінка результатів втручань
та їх корекція
Скарги
пацієнта
Анамнестичні
дані
Об’єктивно
•Підготовка пацієнта до взяття інфікованого
матеріалу для специфічних лабораторних
досліджень
•Підготовка пацієнта та проведення заходів
невідкладної допомоги
•Вирішення проблем та потреб пацієнта
•Виконання лікарських призначень
•Вирішення супутніх проблем пацієнта
•Навчання пацієнта та його оточуючих санітарногігієнічних навичок

medicine
medicine








